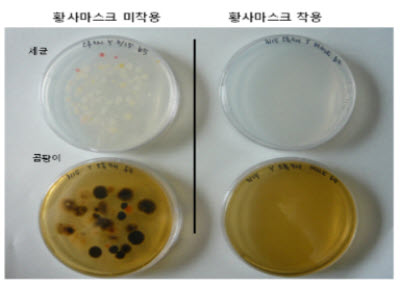

À۳⿡ Ȳ»ç°¡ °üÃøµÈ ³¯Àº ÇÏ·ç(11¿ùÁß)¿¡ ºÒ°úÇÏ¿´À¸³ª ±Ý³â µé¾î¼´Â ¹ú½á 3ÀÏ(3.1, 3.9, 3.10)¿¡ ´ÞÇϰí ÀÖ°í ±â»óûÀº º½Ã¶ Àü¹Ý¿¡ °ÉÃÄ ºÏ¼Ç³À» Ÿ°í Ȳ»ç°¡ ¿ì¸®³ª¶ó·Î À¯À﵃ °¡´É¼ºÀÌ ³ôÀ» °ÍÀ¸·Î Àü¸ÁÇϰí ÀÖ´Ù.
ÀÌ¿¡ ¼¿ï½Ã´Â ´ë±â Áß¿¡ Ȳ»ç°¡ À¯ÀԵǰųª ¹Ì¼¼¸ÕÁö ³óµµ°¡ ³ô¾ÆÁú °æ¿ì °Ç°À» À§ÇØ È²»ç¸¶½ºÅ©¿Í ±ä¼Ò¸Å ÀǺ¹À» Âø¿ëÇÏ´Â µîÀÇ ½Ã¹ÎÇൿ¿ä·ÉÀ» ¾È³»Çß´Ù.
½Ã´Â ´ë±â Áß¿¡ Ȳ»ç°¡ À¯ÀÔµÇ¸é ½Ã¹ÎµéÀÌ ½Ç¿ÜȰµ¿À» ÀÚÁ¦ÇÒ °ÍÀ» ´çºÎÇßÀ¸¸ç, ¿ÜÃâ µî ½Ç¿ÜȰµ¿À» ÇÒ °æ¿ì Ȳ»ç¿Í °°ÀÌ À¯À﵃ ¼ö ÀÖ´Â ¼¼±Õ°ú °õÆÎÀÌ µîÀÇ ¹Ì»ý¹° Â÷´ÜÈ¿°ú°¡ Ź¿ùÇÑ È²»ç¸¶½ºÅ©¸¦ Âø¿ëÇÏ´Â °ÍÀÌ ÁÁ´Ù°í ¹àÇû´Ù.
ÀÏ¹Ý º¸°Ç¸¶½ºÅ©¿Í Ȳ»ç¸¶½ºÅ© °£ÀÇ ¹Ì»ý¹° Â÷´ÜÈ¿°ú¸¦ ½ÇÇèÇÑ ¼¿ï½Ã º¸°Çȯ°æ¿¬±¸¿ø¿¡ µû¸£¸é, ÀÏ¹Ý º¸°Ç¸¶½ºÅ©´Â 80%´ëÀÇ ¹Ì»ý¹° Â÷´ÜÈ¿°ú¸¦ º¸ÀÎ ¹Ý¸é Ȳ»ç¸¶½ºÅ©´Â 98% ÀÌ»óÀÇ ¹Ì»ý¹°À» Â÷´ÜÇÏ´Â È¿°ú¸¦ º¸¿´´Ù.
¼¿ï½Ã º¸°Çȯ°æ¿¬±¸¿ø¿¡¼´Â 2010³â°ú 2013³â(3.8~3.14) 2ȸ¿¡ °ÉÃÄ È²»ç¸¶½ºÅ© 12Á¾, ÀÏ¹Ý º¸°Ç¸¶½ºÅ© 9Á¾ µî 21Á¾ÀÇ ¸¶½ºÅ©¿¡ ´ëÇØ ¼¼±Õ°ú °õÆÎÀÌ Â÷´ÜÈ¿°ú¸¦ ½ÇÇèÇß´Ù.
±× °á°ú ÀÏ¹Ý º¸°Ç¸¶½ºÅ©´Â ¼¼±Õ 88%, °õÆÎÀÌ 83.2%¸¦, Ȳ»ç¸¶½ºÅ©´Â ¼¼±Õ 98.5%, °õÆÎÀÌ 98.8%¸¦ Â÷´ÜÇÏ´Â °ÍÀ¸·Î ³ªÅ¸³ª Ȳ»ç¸¶½ºÅ©¸¦ Âø¿ëÇÏ¸é ´ëºÎºÐÀÇ ¹Ì»ý¹°À» Â÷´ÜÇÒ ¼ö ÀÖÀ½À» ÀÔÁõÇß´Ù.
Ȳ»ç¸¶½ºÅ©´Â °¡±î¿î ¾à±¹À̳ª ÆíÀÇÁ¡¿¡¼ ±¸ÀÔÇÒ ¼ö ÀÖ´Ù. À̶§ Ȳ»ç¸¶½ºÅ©´Â 1ȸ¿ëÀ̹ǷΠ¼¼Å¹ÇÏ¿© Âø¿ëÇϸé È¿°ú°¡ ¶³¾îÁú ¼ö ÀÖ´Ù. ¶ÇÇÑ È²»ç¸¶½ºÅ©¸¦ Âø¿ëÇÑ ÈÄ ¡°ÀǾà¿Üǰ, Ȳ»ç¹æÁö¿ë¡± ¶ó°í Ç¥±âµÇ¾î ÀÖ´ÂÁö ¹Ýµå½Ã È®ÀÎÇÏ°í ±¸ÀÔÇØ¾ß ÇÑ´Ù°í ¸»Çß´Ù.
hyun@schooli.kr